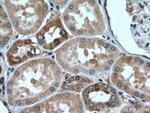
RAB12 Antibody in Immunohistochemistry (Paraffin) (IHC (P))

Search
Proteintech
RAB12 Polyclonal Antibody
{{$productOrderCtrl.translations['antibody.pdp.commerceCard.promotion.promotions']}}
{{$productOrderCtrl.translations['antibody.pdp.commerceCard.promotion.viewpromo']}}
{{$productOrderCtrl.translations['antibody.pdp.commerceCard.promotion.promocode']}}: {{promo.promoCode}} {{promo.promoTitle}} {{promo.promoDescription}}. {{$productOrderCtrl.translations['antibody.pdp.commerceCard.promotion.learnmore']}}
产品信息
18843-1-AP
种属反应
已发表种属
宿主/亚型
分类
类型
抗原
偶联物
形式
浓度
规格
纯化类型
保存液
内含物
保存条件
运输条件
靶标信息
The small GTPases Rab are key regulators of intracellular membrane trafficking, from the formation of transport vesicles to their fusion with membranes. Rabs cycle between an inactive GDP-bound form and an active GTP-bound form that is able to recruit to membranes different set of downstream effectors directly responsible for vesicle formation, movement, tethering and fusion. That Rab may play a role in protein transport from recycling endosomes to lysosomes regulating, for instance, the degradation of the transferrin receptor. Involved in autophagy.
仅用于科研。不用于诊断过程。未经明确授权不得转售。
生物信息学
蛋白别名: putative Ras-related protein Rab-12; Rab-13; Ras-related protein Rab-12
基因别名: 2900054P15Rik; AW555448; C77700; RAB12
UniProt ID: (Human) Q6IQ22, (Mouse) P35283
Entrez Gene ID: (Human) 201475, (Mouse) 19328